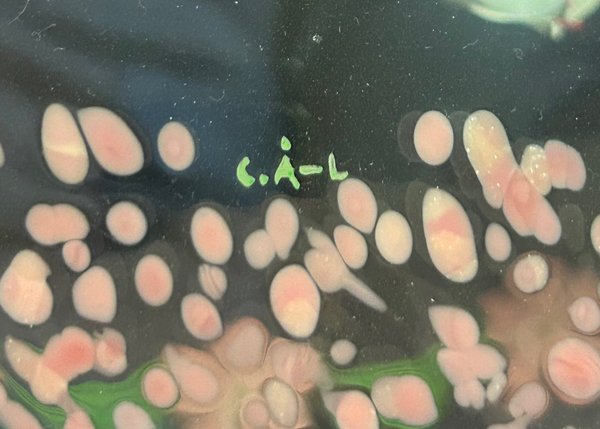
galleryimage 3

Lindshammar glasskål – Cattis Åselius Lidbeck
Slutar 16 nov 19:37
Utropspris
∙0 bud
130 kr
139 kr med köparskydd.
Fraktpris inom Sverige
72 kr DHL
Samfrakt
3 dagarAlla betalningar granskas av Tradera för din säkerhet.
Direktbetalning | Delbetalning | Faktura
Köparskyddet gäller alla betalsätt
1/0

Beskrivning
Vacker handmålad glasskål från Lindshammar glasbruk, design Cattis Åselius Lidbeck.
• Mått: Ø ca 19 cm, höjd ca 15 cm
• Signerad C.Å-L
• Design: Cattis Åselius Lidbeck
• Färg: Rosa med handmålad blommönstrad dekor
• Skick: I fint skick i övrigt, men med två väldigt små naggar i överkant (se 2 sista bilderna)
Se mina andra annonser. Samfraktar gärna.
• Mått: Ø ca 19 cm, höjd ca 15 cm
• Signerad C.Å-L
• Design: Cattis Åselius Lidbeck
• Färg: Rosa med handmålad blommönstrad dekor
• Skick: I fint skick i övrigt, men med två väldigt små naggar i överkant (se 2 sista bilderna)
Se mina andra annonser. Samfraktar gärna.
























